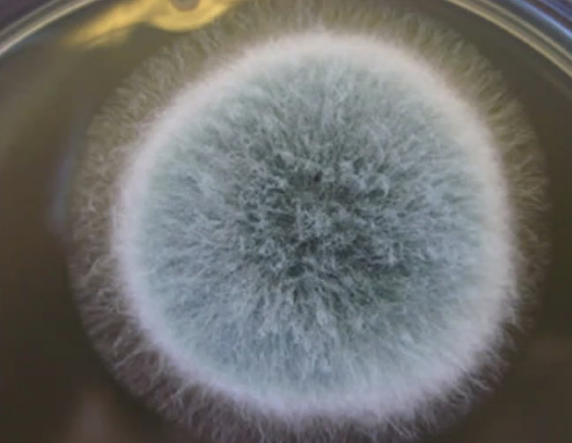
<p>What is shown?</p>

Skin Fungus Part 1
1/30
There's no tags or description
Looks like no tags are added yet.
Name | Mastery | Learn | Test | Matching | Spaced |
|---|
No study sessions yet.
31 Terms
How do fungi survive?
decomposing and utilizing organic matter (carbon-based)
What is the study of fungi?
mycology
What can fungi grow as?
yeasts, molds, dimorphic (yeast and mold forms)

What is shown?
hypha/hyphae (tubular filaments bounded by cell walls)
What is shown?
Mycelium (round arrangement of hyphae)
What are the sacs that fill with spores that are outgrowths?
sporangium/a
What are the reproductive and infectious bodies that spread the fungus?
Spores/sporidium
How do single fungal cells divide (yeast)?
budding or binary fission
Is budding equal or unequal splitting?
unequal splitting
Is binary fission equal or unequal splitting?
equal
How is yeast classified?
byits method of reproduction or dividing
How do we classify mold?
by hyphae shape
What is morphology when classifying molds?
parallel or nonparallel walls
What do we look at when classifying molds hyphal?
morphology, septation/divisions, branching, pigmentation
How are molds further classified?
by their spore and its shape
What are fungal environmental requirements?
moisture, warmth, available food source (potassium, phosphorus, magnesium, sulfur, amino acids, vitamins, and fatty acids)
What is the yeast infection, typically in the ears, has an odor, and waxy discharge?
malassezia pachydermatis
How can we remember malassezia pachydermatis?
pachderm= elephant

What yeast infection is shown?
malassezia pachydermatis
Besides ears, what else can malassezia pachydermatis effect?
skin folds

What is the yeast infection that is painful and in the oral cavity/throat?
candida albicans (thrush)

What yeast infection is shown?
candida albicans (thrush)
What are dermatophytes?
skin fungi
What does ringworm require for growth? Therefore, where do they grow?
keratin- skin, hair, nails
What genus do ringworm fungi come from?
microsporum, trichophyton, epidermophyton

What is shown?
dermatophytes or ringworm
What is the growth pattern of ringworm?
expanding outward in a ring pattern as it uses keratin
T/F: The center of ringworm can never heal or regrow hair.
False- it can be treated
What occurs in chronic infection, when hairless skin becomes thickened and rough?
lichenification
What is the order for ergot drom claviceps purpurea?
animal ingests contaminated grain, mycotoxins spread, vasocontriction, skin necrosis → coagulation necrosis
What does ergot cause?
death of tissue or possibly hooves (degloving)